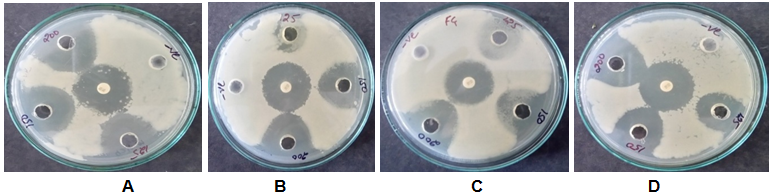
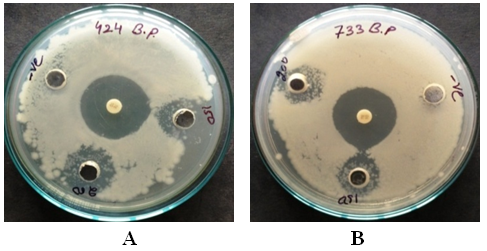

Department of Biotechnology, G. B Pant Engineering College, Pauri Garhwal
Email: ajeetsoniyal@gmail.com
Received: 21 Jul 2016, Revised and Accepted: 20 Aug 2016
ABSTRACT
Objective: To isolate the antibacterial proteins/peptides from Ficus glomerata leaf.
Methods: Present study was designed to investigate antibacterial activity of proteins/peptides isolated from Ficus glomerata leaf. The isolated proteins/peptides were further checked for antibacterial activity against, Pseudomonas aeruginosa, Bacillus subtilis, Escherichia coli and Salmonella entrica bacterial pathogens.
Results: The results indicates that a 35kDa of protein were identified and exhibit good antibacterial activity against bacterial pathogen among all strains, Salmonella entrica and Pseudomonas aeruginosa exhibit good results with a clear zone of inhibition.
Conclusion: Ficus glomerata is popular for its medicinal properties against therapeutic potential. In the present study a novel protein with broad spectrum antibacterial activity. Microbes cause severe damage to plants which results in a large economic loss so; this protein can be use as an active agent in agriculture for plant protection and also in the development of novel therapeutic agents.
Keywords: Ficus glomerata, SDS-PAGE, Antimicrobial protein (AMPs), Antibacterial protein/peptide
© 2016 The Authors. Published by Innovare Academic Sciences Pvt Ltd. This is an open access article under the CC BY license (http://creativecommons.org/licenses/by/4.0/)
DOI: http://dx.doi.org/10.22159/ijcpr.2016v8i4.15271
INTRODUCTION
Since a long time period, medicinal plants have been a valuable source for the treatment of several disorders and possible source of antimicrobial agents. Application of medicinal plants and their products for the treatment of various human afflictions had been made by man since ancient time [1].
Ficus glomerata is a widely popular medicinal plant in India and its extracts have also been reported to possess significant various medicinal and pharmacological properties like anti-cancer, antimicrobial, and antioxidant activity [2]. Antibacterial properties of protein/peptide from Ficus glomerata were not reported till now and because of its high antibacterial activity, we took this plant for isolation of antibacterial protein/peptide. This plant can be used to determine bioactive natural products in the form of antimicrobial proteins/peptides, and that may serve for the development of new pharmaceuticals [3]. Protein and peptide were used in different disease states like cancer, diabetes, immuno-modulating, neuro-degenerative effects as drug targeting to the specific site [4].
Most of the natural antimicrobial peptides are a range in size from 2 to 50 kDa and have 10 to 50 amino acids in length and are positively charged, shows the helical structure and often contain a high position of hydrophobic amino acid [5]. Antimicrobial peptides are a group of numerous endogenous antibiotics and innate immune components that protect hosts against microbial infection and are produced predominantly in the natural environment. Hundreds of AMPs have been isolated from plants, insects, bacteria, fungi, mammals and so on [6] Despite the fact that plants do not have an immune system, they have developed a variety of potent defensive mechanisms, along with the synthesis of, proteins, low-molecular-weight compounds and peptides with antifungal activity gradually.
This type of arrangement results in peptide attachment and insertion into the bacterial membrane to form trans membrane pores leading to membrane permeabilization. The amphipathic nature of antimicrobial peptides is needed for this method, as hydrophilic ion groups, it interacts with phospholipid groups additionally found within the membrane, while hydrophobic motifs directly interact with lipid elements of the membrane. The antifungal activity of AMP was initially ascribed to either fungal cell lysis or interference with fungal cell wall synthesis. Plant antifungal proteins comprise enzymes such as chitinases [7, 8] and β-1-3-glucanases [9] which can collaborate with membrane elements such as lipid transfer proteins (LTPs) [10], glycine/histidine-rich proteins, defensins [11-13] cyclophilin-like proteins and thaumatin-related protein [14-16]. The first antibacterial peptide was isolated from wheat flour, which has the potential to inhibit the growth of some phytopathogens such as, Corynebacterium michiganense, Xanthomonas campestris, and Pseudomonas solanacearum [17]. According to amino acid sequence homology, the main families of AMPs are thionins, defensins, cyclotides, snakins, have in like proteins and lipid transfer proteins, AMPs have been demonstrated to cease prokaryotic cells by targeting a variety of essential or metabolic processes at extracellular, intracellular sites and plasma membrane [18]. In silico study revealed some similarities in tertiary structures of antimicrobial plant proteins, although significant differences in amino acid sequences between the families.
Key features of AMPs are a high content of cysteine and glycine and the presence of disulfide bonds, which are important for intensifying structural stability under stress conditions. Small peptides are usually made in a cell either as precursor proteins or non-precursor proteins. The precursor protein can possess functional significance or be nonfunctional. The term nonfunctional is referring for those having no recognized, biological activity. The non-precursor-derived peptides encoded by sORFs are located in or near five regions of a gene [19]. Some antimicrobial peptides (AMPs) are made as precursor proteins that need to be processed to produce a functional peptide.
MATERIALS AND METHODS
Bacterial strain
Bacterial strains P. aeruginosa (424), B. subtilis (441), S. entrica (733) and E. coli (739) were collected from Microbial Type Culture Collection (MTCC), Institute of Microbial Technology (IMTECH), Chandigarh, India.
Medicinal plants
The Ficus glomerata leaves were collected from Haridwar, Uttarakhand.
Sample preparation
Plant leaves were first clean with tap water in order to remove all dirt and debris, later with distilled water. They were dried with tissue paper, cut in small pieces and were grinded in mortar pestle to make a fine powder.
Extraction of antibacterial protein/peptide
Fresh 5 gm of leaves were grinded using extraction buffer 50 mmol Tris-HCl (pH 7.5) and 0.5 M NaCl [20], after complete homogenization of leaves, kept the sample for 12 hr incubation period. After that, spin at 12,000rpm for 20 min in a cooling centrifuge. After centrifugation, the resulting supernatant was investigated for further studies.
Evaluation of total protein concentration by bradford assay
Total protein content of the Ficus glomerata leaf extract was estimated spectrophotometrically by Bradford method using BSA stock solution (2 mg/ml) at 595 nm [21].
Antibacterial activity assay
Antibacterial test of protein from Ficus glomerata leaves was done against pathogens P. aeruginosa (424), B. subtilis (441), S. entrica (733) and E. coli (739) by Agar well diffusion method [22]. The strain of each bacterium was swabbed equally onto the Petri plates having Nutrient agar media. Wells were made by the help of borer. The sample was loaded onto each wells of different concentration using sterile micropipette. Incubate at 32 °C for 24 h. Then zone of inhibition was measured.
SDS-page
Sodium dodecyl sulphate-polyacrylamide was carried out according to the Laemmli method [23]. The sample for analysis was dissolved in sample buffer (0.125M Tris pH 6.8, 2.5% SDS, 20%glycerol, 0.002%bromophenol blue, 10%β-mercapto-ethanol) boiled for 5 minutes. The supernatant (35µg) of protein sample was loaded onto the gel. Gel consisting of 10% resolving gel and 10% stacking gel using electrophoresis unit (Bio-Rad) to get the separated peptides of different molecular weight. Electrophoresis was performed with 100V until reached the bottom of the resolving gel. After this, gel was stained with Comassive Brilliant Blue R-250 and destain with 40% methanol and 10% glacial acetic acid solution. Different bands resulted after destaining. The molecular mass of antibacterial protein/peptide was determined by the molecular marker.
RESULTS
The present study was focused on the isolation of antibacterial activity conferring protein from the Ficus glomerata leaves. They are identified as important components of the innate defense system of bacteria, fungi, insects, animals and plants. Leaves sample were used for further analysis.
Antimicrobial activity of protein extract
The antibacterial activity of the crude protein extract from leaves was determined by Agar well diffusion assay. Antibacterial activity of plant extract with extraction buffer was tested against different bacterial strains. Among all strains, Salmonella entrica and Pseudomonas aeruginosa exhibit good results with a zone of inhibition 18±1.24 and 19.6±1.44.
Table 1: Zone of inhibition (mm) of protein extract against bacterial pathogen
| Pathogens | Negative control | Tetracycline (Positive control) | 200 µl |
| Pseudomonas aeruginosa | 0 | 13 | 19.6±1.44 |
| Escherichia coli | 0 | 13 | 18.3±1.65 |
| Salmonella enterica | 0 | 13 | 18±1.24 |
| Bacillus subtilis | 0 | 13 | 17.3±1.90 |
Fig. 1: Antibacterial activity of crude protein against different bacterial pathogens, ‘A’ shows antibacterial activity against Pseudomonas aeruginosa, ‘B’ shows against Bacillus subtilis, ‘C’ shows against Escherichia coli and ‘D’ shows against Salmonella enteric
Sodium dodecyl sulphate-polyacrylamide gel electrophoresis
Proteins were run on an SDS-PAGE. The migration of molecular mass standards is indicated in kDa on the left-hand side. On the basis of Bradford results, the total amount of protein were determined, and 33µg of protein was loaded on wells. The molecular profiling of sample was observed and indicates the presence of a protein with a molecular weight ranging from 8 kDa to 245 kDa and according to the previously reported studies the protein bands distinguish in this study was used for the further activity.
Antibacterial activity of eluted protein sample
To check the antibacterial activity of protein band, it was first eluted by elution buffer, further test against different bacterial pathogens. As shown in fig. 3 ‘A’ shows a clear zone of inhibition of 12 mm at 150 µl of protein content and 14 mm at 200 µl of eluted protein content against bacterial pathogen Pseudomonas aeruginosa. Same as ‘B’ found to be very effective on Salmonella entrica. with a zone of inhibition 12 mm with 150 µl of protein and 14 mm at 200 µl of protein, the negative control is Tris-Cl (pH=8).

Fig. 2: SDS-PAGE analysis of protein extracted from Ficus glomerata leaf. 35µg of protein were loaded in each well, lane of molecular weight marker indicated at the left
Fig. 3: This fig. shows antibacterial activity of small protein/peptide having molecular weight 35 kDa against two pathogenic strain Pseudomonas aeruginosa and Salmonella entrica
Statistical analysis
All the experiments were carried out in triplicate thrice (n=3). The statistical analysis of the data was carried out by analysis of the variance (ANOVA). Results were considered significant when p<0.05.
DISCUSSION
This study described the isolation of antimicrobial protein from ficus glomerata leaf; we found that the isolated protein exerted strong antibacterial activity against gram positive and gram negative bacteria that is Bacillus subtilis and Pseudomonas aeruginosa with a high zone of inhibition to control diseases and enhance the growth of the early plant.
In the previous study, antimicrobial peptides with gram positive and gram negative bacteria growth inhibiting ability have been reported [24]. Numerous types of molecules with antibacterial activity have been isolated from plants [25, 26].
According to the World Health Organization (WHO), medicinal plants would be the capable source to obtain a variety of active compounds and drug. Therefore, such plants should be investigated to finer understand their properties, efficiency and safety [27]. Hence an attempt is made to explore the possible antimicrobial peptides generated through the medicinal plant. In previous studies, A 7.8 kDa of antimicrobial protein was isolated from the Seeds of Motherwort [28]. Similar to our study we found 35 kDa of protein isolated from Murraya Koenigii [29].
Several Amps have been reported, purified and characterized by using a large variety of techniques like, ion exchange chromatography, RP-HPLC those are quite expensive and time-consuming [30, 31]. Here, we have isolated the antibacterial proteins/peptides from Ficus glomerata leaf by cost-effective and time-saving methods for plant protection and therapeutic potential.
CONCLUSION
It is concluded that the traditional plants may represent new sources of antimicrobials with the use of AMPs as single therapeutic antibiotic agents. In the current study, a novel antimicrobial protein was identified from Ficus glomerata leaf. The results showed that 35kDa of protein were identified and exhibit broad spectrum antibacterial activity against bacterial pathogen and can further use to develop novel therapeutic agents and biologically active component in agriculture as plant protection agents.
ACKNOWLEDGEMENT
The authors are thankful to Govind Ballabh Pant Engineering College, Pauri-Garhwal to provide lab facility and TEQIP II for a financial assistantship.
CONFLICT OF INTERESTS
Declare none
REFERENCES
How to cite this article